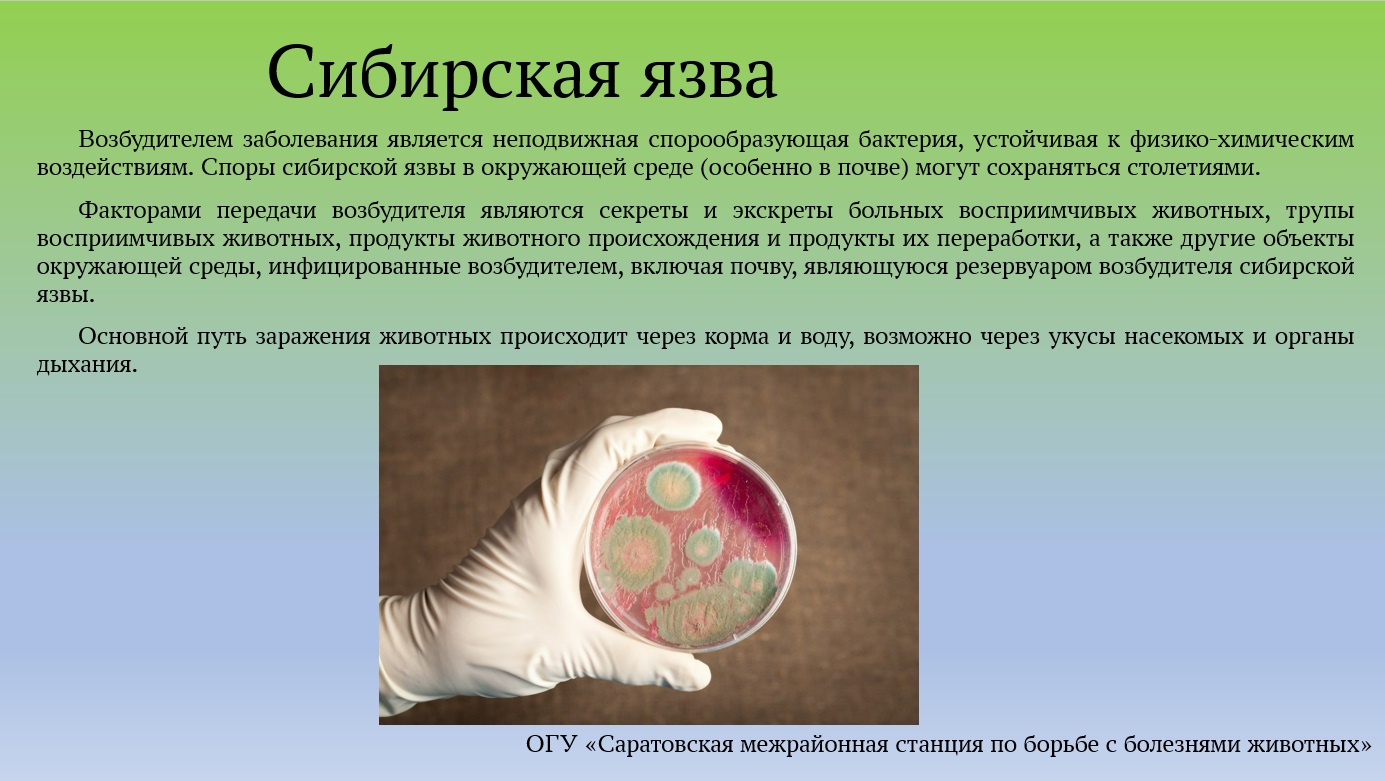

Язва ямал
Теннис пекин мужчины турн сетка
Дети морти
Linux debian интерфейс
Толстолобик на что клюет осенью
Техническое содействие это
Galaxy store обновить
Steam tools games
Колли недорого
1 в ресторанах и барах
Wasabi таганрог меню
Открытка с днем преподавателя колледжа
Электричка станция власово
Включи щекотать пятки
Язва ямал 117 фото